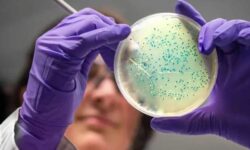

नयाँ दिल्ली । भारतका केन्द्रीय इलेक्ट्रोनिक्स तथा सूचना प्रविधिमन्त्री अश्विनी वैष्णवले सन् २०२६ देखि भारतमा सेमिकन्डक्टर चिपको व्यावसायिक उत्पादन शुरू...
न्यूयोर्क । अमेरिकामा आइफोन प्रयोगकर्ताका बैंक खातामा आइफोन निर्माता कम्पनी एप्पल स्वयंले रकम जम्मा गरिदिएको छ । आइफोनमा प्रयोग हुने...
लण्डन । चीनको शिजियान–३२ उपग्रह प्रक्षेपण गर्ने प्रयास असफल भएको छ । शिजियान– ३२ प्रक्षेपण दक्षिण–पश्चिमी सिचुआन प्रान्तमा अवस्थित सिचाङ...
काठमाडौं । सामसङ नेपालले नयाँ ग्यालेक्सी एस २५ एफई सार्वजनिक गरेको छ । नयाँ फोनमा युवा प्रोफेसनल्स र कन्टेन्ट क्रिएटर्सका...
नयाँ दिल्ली । भारतले सन् २०२५ को अन्त्यसम्म व्यावसायिक सेमिकन्डक्टर उत्पादन सुरु गर्ने भएको छ । मंगलबार भारतीय प्रधानमन्त्री नरेन्द्र...
काठमाडौं । सामसुङले नेपालमा आफ्नो लोकप्रिय ए सिरिजलाई विस्तार गर्दै नयाँ ग्यालेक्सी ए १७ ५ जी सार्वजनिक गरेको छ ।...
लण्डन । आर्टिफिसियल इन्टेलिजेन्स (एआई)ले दुई नयाँ एन्टिबायोटिक विकास गरेको छ । यसले एन्टिबायोटिक प्रतिरोधी क्षमता विकास गरेका गोनोरिया र...
लण्डन । युट्युबले आफ्नो मुद्रीकरण नीति अपडेट गर्न लागेको जनाएको छ । नयाँ नीति जुलाई १५, २०२५ देखि लागू हुनेछ...
काठमाडौं । कपिराइटको अभियोगमा नेपाल टेलिभिजनको आधिकारिक युट्युब च्यानल डिलिट भएको पाइएको छ । बारम्बार प्रतिलिपि अधिकार उल्लंघन गरेपछि नेपाल...
काठमाडौं । दर्ता गर्ने विषयमा नेपाल सरकार फेसबुकप्रति लचक बनेको छ । चैत ७ गते एक महिनाको समय सकिएपछि सरकारले...
काठमाडौं । सामसङ ग्यालेक्सी एस २५ अल्ट्रा मोबाइल नेपाली बजारमा सार्वजनिक भएको छ । ग्यालेक्सी एस २५ अल्ट्रा १ टीबी...
लण्डन । गुगलले आफ्नो खोज ईञ्जिनमा नयाँ अपडेट सार्वजनिक गरेको छ । कृत्रिम बुद्धिमत्ता (एआई) मोडलाई तस्वीरहरूको विश्लेषण गर्न सक्षम...